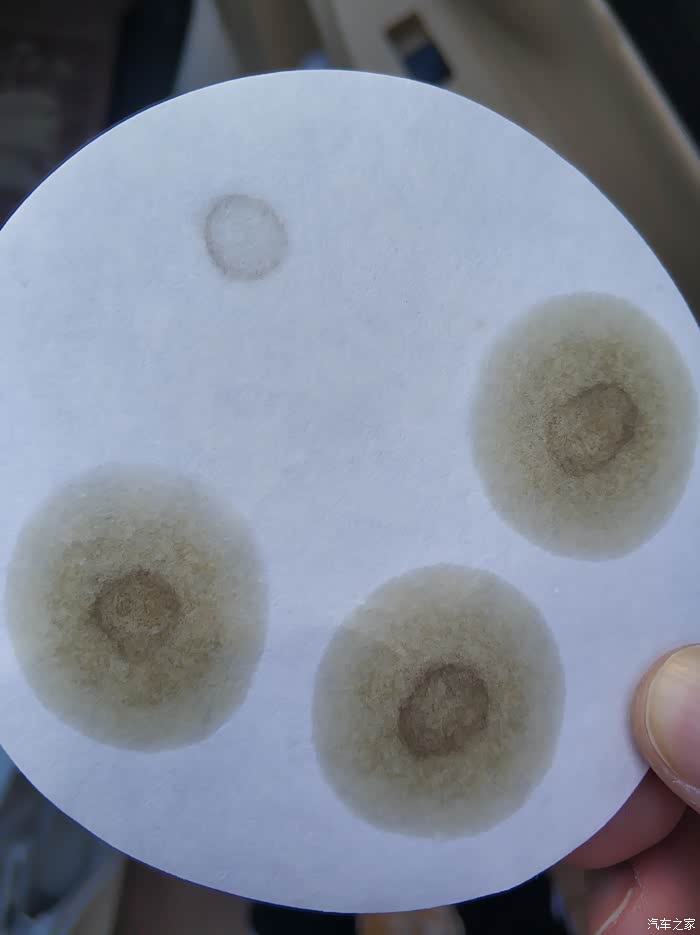

-
-
-
2021-11-22 10:06:44 IP
我一般每次在换机油前加燃油添加剂 然后跑个高速 等一箱油用完了去做个保养
-
2021-11-22 10:06:58 IP怎么看燃油宝好不好用?我烧了四锅了。
-
2021-11-06 18:18:06 IP
实践出真知啊!
-
2021-11-25 17:02:18 IP这是停用燃油宝,跑了一箱汽油,然后换了新机油新机滤的前提下,跑了2000公里测的油样。被洗下的积碳依然可见,混合在机油里,不知机滤能过滤到什么程度,堵没堵。
机油美孚afe,机滤马勒。
-
2021-08-22 22:04:24 IP添加剂不就是为了清理积碳么?清理下来的积碳不会百分百和废气一起排出去,进入到机油那不是必然的么?只要机滤合格,应该没什么太大问题,反正我现在已经连续用了快一万公里了,还是有好处的
-
2021-08-23 10:20:14 IP
机油就是用来被污染的
-
2021-08-22 21:03:37 IP
所以本帖的前提是,燃油稀释机油都是正常现象?
-
-
2021-08-22 22:05:45 IP
燃油宝污染机油只是会出现在PEA上,
参看
https://chejiahao.autohome.com.cn/info/9360466?r=20210822220518
-
2021-08-23 10:02:10 IP机油有一项作用就是清洗,你pea加进去肯定杂质洗到机油里了,你就算不加pea,他还是要被燃烧物逐渐污染,机油勤换一点的好
-
2021-08-22 23:00:52 IP同楼主一样,丰田歧管喷射1.6机头,用了龙润送的添加剂,机油里同样出现黑色粉末
-
2021-11-08 18:43:55 IP
看来缸内积碳严重的车,不适合大剂量PEA除积碳,宁可慢也不能猛
-
2021-11-08 18:48:53 IPpea不污染机油,pea只是积碳的搬运工
-
2021-11-08 19:26:44 IP哦吼....上个月我刚刚换完机油 然后才加的添加剂!看来我也要被污染了?会有什么隐患吗
-
2021-11-07 21:28:36 IP这是因为机滤旁通阀打开了吗
-
2021-11-07 22:14:18 IP

机油尺擦下来的,沥青样,有粘性,无颗粒感。0.1%已连续20箱油。
[本回复最后由 xjbgly 于2021-11-07 22:17:13 编辑] -
2021-11-14 21:43:35 IP
积碳多的车子剂量看来真得小一点
-
2021-11-19 16:56:10 IP
正常啊,积碳都被洗下来了。污染机油没问题的,大颗粒会被机滤过滤掉。小的对发动机没损坏

游客
游客










